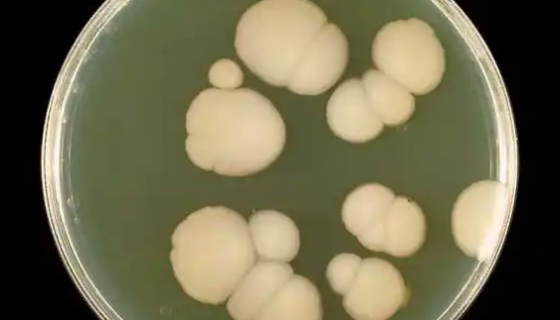
白色涅斯特连科氏菌的培养与使用及注意事项！

茄拉尔氏菌的形态特征与主要价值及培养方法!
茄拉尔氏菌是Ralstonia属的微生物,原产地为中国。菌体...

ACCC 50632 蛹虫草(北冬虫夏草、北虫草)
蛹虫草是食药两用真菌,其蛋白质含量高达40.7%,其中所含人...

小鼠胚胎干细胞接受后的处理与培养方法!
小鼠胚胎干细胞ES-R1/E取自129X1/SvJ x 12...

人髓母细胞瘤细胞的处理方法与培养步骤!
人髓母细胞瘤细胞系是1984年由Friedman等建立的;在...

威尔酵母——利用亚硫酸盐废液酒精发酵
威尔酵母,生物,菌类,盘菌科。主要用于利用亚硫酸盐废液酒精发...

蓝色犁头霉的培养条件与注意事项及打管说明!
蓝色犁头霉,菌落棉絮状,初淡蓝色,后紫蓝色,最后带深灰青褐色...

鼠李糖乳杆菌——用于发酵乳品及相关发酵食品
鼠李糖乳杆菌( Lactobacillus rhamnosu...

小鼠颈动脉内皮细胞的培养操作步骤及注意事项!
内皮细胞层是血液和其它组织的天然屏障。内皮细胞功能是造成的主...
白色涅斯特连科氏菌的培养与使用及注意事项!
白色涅斯特连科氏菌是Nesterenkonia属的微生物,原...